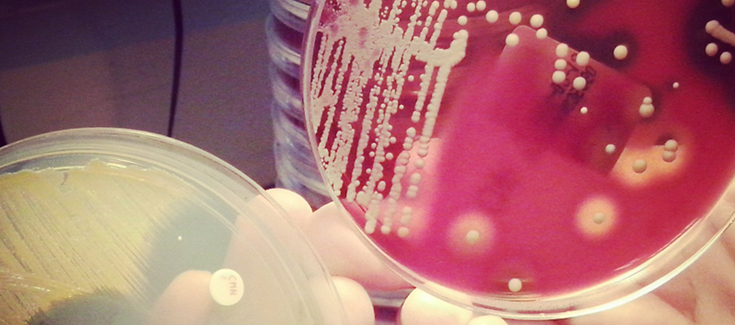

El año 2019 el grupo de investigación de Innovación en Infecciones Respiratorias y Diagnóstico de la Tuberculosis del Instituto de Investigación Germans Trias y Pujol (IGTP) -coliderado por los investigadores del CIBERES Cristina Prat-Aymerich y José Domínguez - publicaron un estudio sobre el encapsulamiento del antibiótico rifampicina en nanopartículas PLGA (ácido poli-láctico-co-glicólico), de manera que llegaba más fármaco a la diana que administrándolo solo. Utilizaron un modelo que simula la liberación del fármaco por vía oral. Demostraron que las nanopartículas protegen el antibiótico de los ácidos del estómago, que normalmente destruyen un 25% de la dosis, permitiéndole llegar al flujo sanguíneo y liberar lentamente el tratamiento. En este caso la rifampicina se utilizó para tratar Mycobacterium tuberculosis, el microorganismo causante de la tuberculosis.
En este estudio han utilizado una tecnología similar, esta vez para tratar la bacteria Staphylococcus aureus con cloxacilina encapsulada. S. aureus es un microorganismo que se encuentra en el tracto respiratorio superiore en un 30% de los individuos sanos pero que puede desarrollar diferentes condiciones, desde casos en que los individuos son portadores, pero no muestran síntomas, hasta afecciones mortales como la sepsis. Además, S. aureus resistente a la meticilina (MRSA por las siglas en inglés) es la causa de un número creciente de infecciones que no se pueden tratar con antibióticos estándar, especialmente en entornos hospitalarios.
En este nuevo estudio, el equipo de Cristina Prat-Aymerich y José Domínguez en el IGTP han trabajado de nuevo con el grupo de investigación de Manuel Arruebo en la Universidad de Zaragoza. El estudio es un proyecto colaborativo entre CIBERES, CIBER-BBN y SEPAR; el artículo de ha publicado en Nanomedicine.
"Este segundo estudio es importante porque muestra que esta tecnología tiene el potencial para usarse para combatir distintos tipos de bacterias", explica Alicia Lacoma, investigadora postdoctoral CIBERES en el IGTP, primera autora del estudio. Las nanopartículas que contienen fármacos muestran una buena actividad antimicrobiana en condiciones ácidas y neutrales. Liberan el antibiótico lentamente y no dañan las células circundantes. "Esta tecnología no es solo efectiva contra MRSA, su uso generalizado permitiría una acción dirigida de los antibióticos solamente en el punto de la infección, cosa que reduciría todavía más la expansión de bacterias resistentes y los efectos secundarios. El siguiente paso es comparar el efecto de la cloxacilina sola o dentro de las nanopartículas en S. aureus susceptible y resistente, en un modelo de neumonía de ratón", concluye.
Artículo original
Novel intracellular antibiotic delivery system against Staphylococcus aureus: cloxacillin-loaded poly(d,l-lactide-co-glycolide) acid nanoparticles
Alicia Lacoma et al, Nanomedicine, Published Online:6 May 2020, https://doi.org/10.2217/nnm-2019-0371
Artículo relacionado
‘Matrioskas’ de nanopartículas, una nueva aproximación terapéutica contra la tuberculosis